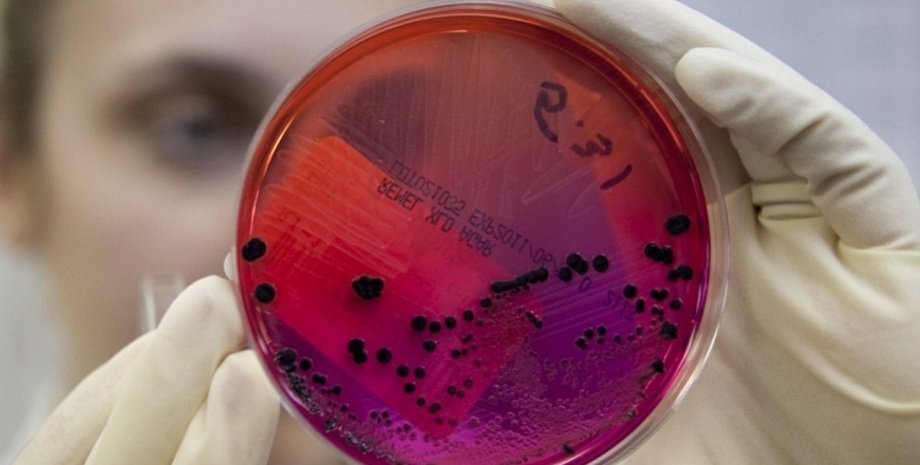
Фото из открытых источников

СМИ: На Сумщине госпитализировали женщину с подозрением на сибирскую язву
Сейчас проводятся анализы
В Сумской области госпитализировали жительницу села Мирополье Краснопольского района с подозрением на сибирскую язву. Об этом сообщает местное издание СпецКор со ссылкой на главного врача-инфекциониста Сумской области Ирину Троцкую.
Для подтверждения диагноза у больной взяты анализы, которые отправили на бактериологическое исследование. Больная родом из села Мирополье, где недавно обнаружили сибирскую язву у умерших животных, поэтому болезнь врачи и заподозрили.
"Окончательного диагноза больной еще не установили, ведь нет результатов анализов", - отметила главный врач-инфекционист Сумской области Ирина Троцкая.
Напомним, что в конце июня в селе Мирополье Краснопольского района обнаружили сибирскую язву в трупах овец, которых нашли местные жители вблизи реки. Животные были спрятаны в пластиковые мешки и прикопанные землей. Экспертиза подтвердила болезнь.
Все останки животных сожгли, а почву продезинфицировали.
В селе введен 15-дневный карантин. Ветеринары проверяют скот и проводят прививки.
